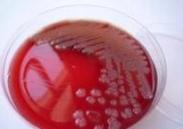

嗜水氣單胞菌感染癥狀
628健康網(wǎng)(m.xgzic.com)為您匯集最新關(guān)于嗜水氣單胞菌感染癥狀的健康知識(shí)大全、嗜水氣單胞菌感染癥狀最新消息資訊等有關(guān)嗜水氣單胞菌感染癥狀的文章知識(shí)介紹,供您參考。
嗜水氣單胞菌感染癥狀
-
嗜水氣單胞菌感染
628健康網(wǎng)為您分享有關(guān)嗜水氣單胞菌感染的癥狀,嗜水氣單胞菌感染的治療方法,嗜水氣單胞菌感染的預(yù)防知識(shí),嗜水氣單胞菌感...
-
云杉根小蠹
基本信息類(lèi)屬:鞘翅目小蠹科分布分布于新疆和四川。形態(tài)特征成蟲(chóng)體長(zhǎng)約4.5mm,黑褐色,稍有光澤,剛毛稀少。額部狹長(zhǎng),...
-
視神經(jīng)萎縮
628健康網(wǎng)為您分享有關(guān)視神經(jīng)萎縮的癥狀,視神經(jīng)萎縮的治療方法,視神經(jīng)萎縮的預(yù)防知識(shí),視神經(jīng)萎縮的癥狀圖片,視神經(jīng)萎縮...
-
曹玉璋
曹玉璋,男,中國(guó)中醫(yī)科學(xué)院西苑醫(yī)院,綜合科,副主任醫(yī)師,醫(yī)學(xué)博士。擅長(zhǎng)運(yùn)用中西醫(yī)結(jié)合的方法診治心血管內(nèi)科常見(jiàn)病...
-
指甲-髕骨綜合征
628健康網(wǎng)為您分享有關(guān)指甲-髕骨綜合征的癥狀,指甲-髕骨綜合征的治療方法,指甲-髕骨綜合征的預(yù)防知識(shí),指甲-髕骨綜合征的...